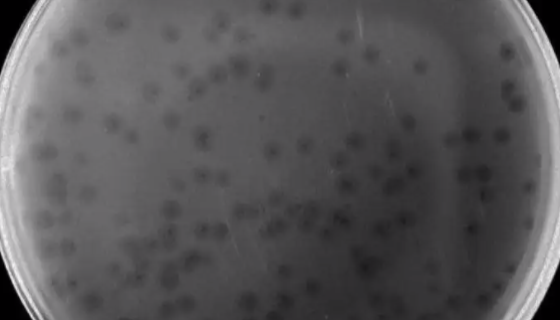
杀鲑气单胞菌亚种冻干管打管说明书！

小鼠视网膜微血管周细胞的使用与培养操作步骤!
视网膜微血管周细胞是视网膜微血管的重要组成部分,与内皮细胞及...

啤酒酵母菌 国家标准菌种 CMCC(B)98007
啤酒酵母是啤酒生产上常用的典型的上面发酵酵母。菌体维生素、蛋...

TCAM-2人睾丸精原瘤细胞的培养步骤与操作方法!
人睾丸精原瘤细胞仅用于科学研究或者工业应用等非医疗目的不可用...

人淋巴内皮细胞的复苏与传代及冻存操作步骤!
人淋巴内皮细胞(HLEC)提取于人淋巴结组织,原代冻存。每管...
杀鲑气单胞菌亚种冻干管打管说明书!
杀鲑气单胞菌亚种是Aeromonas属的微生物,原产地为中国...

人视网膜色素上皮细胞培养方法及操作步骤
hTERT-RPE1,人视网膜色素上皮细胞

人类星型胶质细胞瘤接收后的处理方法与培养步骤!
星形胶质细胞(astrocyte),是哺乳动物脑内分布最广泛...

干酪乳杆菌的菌株特性与主要应用及保存方法!
干酪乳杆菌(L.casei)为短杆状或长杆状的多形性杆菌,长...

ATCC 51299 粪肠球菌耐万古霉素 百欧博伟生物
耐万古霉素肠球菌指肠球菌在使用糖肽类抗菌药物(万古霉素)治疗...